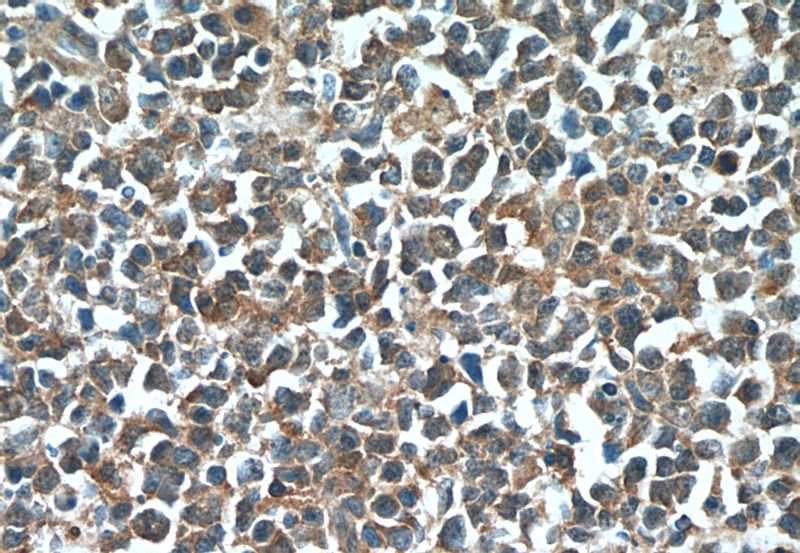
Immunohistochemistry of paraffin-embedded human tonsillitis tissue slide using Catalog No:111839(IRF7 Antibody) at dilution of 1:50 (under 40x lens)

-
Product Name
IRF7 antibody
- Documents
-
Description
IRF7 Rabbit Polyclonal antibody. Positive IP detected in HEK-293 cells. Positive WB detected in HEK-293 cells. Positive IHC detected in human tonsillitis tissue. Observed molecular weight by Western-blot: 80 kDa
-
Tested applications
ELISA, WB, IHC, IP
-
Species reactivity
Human; other species not tested.
-
Alternative names
interferon regulatory factor 7 antibody; IRF 7 antibody; IRF 7H antibody; IRF7 antibody; IRF7A antibody
-
Isotype
Rabbit IgG
-
Preparation
This antibody was obtained by immunization of IRF7 recombinant protein (Accession Number: XM_005252906). Purification method: Antigen Affinity purified.
-
Clonality
Polyclonal
-
Formulation
PBS with 0.02% sodium azide and 50% glycerol pH 7.3.
-
Storage instructions
Store at -20℃. DO NOT ALIQUOT
-
Applications
Recommended Dilution:
WB: 1:200-1:2000
IP: 1:200-1:2000
IHC: 1:20-1:200
-
Validations

HEK-293 cells were subjected to SDS PAGE followed by western blot with Catalog No:111839(IRF7 Antibody) at dilution of 1:600

IP Result of anti-IRF7 (IP:Catalog No:111839, 4ug; Detection:Catalog No:111839 1:600) with HEK-293 cells lysate 3200ug.
Immunohistochemistry of paraffin-embedded human tonsillitis tissue slide using Catalog No:111839(IRF7 Antibody) at dilution of 1:50 (under 40x lens)
-
Background
IRF-7 (interferon regulatory factor 7) is a member of the interferon regulatory transcription factor (IRF) family. IRF-7 has been shown to play a role in the transcriptional activation of virus-inducible cellular proteins, including interferon beta chain proteins. Inducible expression of IRF-7 is largely restricted to lymphoid tissue. Four transcript variants encoding distinct isoforms (A,B,C and D) have been identified for this (PMID:9786932).The active IRF7A exists as a dimer form ~80 kDa(PMID:11073981). The MW 67-70 kDa has been reported in some papers (PMID:9786932; 22951831).Various posttranslational modifications of IRF7 including phosphorylation, ubiquitination, sumoylation and acetylation are identified (PMID:22951831).This antibody is a rabbit polyclonal antibody raised against the C-terminal 349 amino acid residues of human IRF7 D.
-
References
- Weng XG, Song QJ, Wu Q, Liu MC, Wang ML, Wang JF. Genetic characterization of bovine viral diarrhea virus strains in Beijing, China and innate immune responses of peripheral blood mononuclear cells in persistently infected dairy cattle. Journal of veterinary science. 16(4):491-500. 2015.
Related Products / Services
Please note: All products are "FOR RESEARCH USE ONLY AND ARE NOT INTENDED FOR DIAGNOSTIC OR THERAPEUTIC USE"
